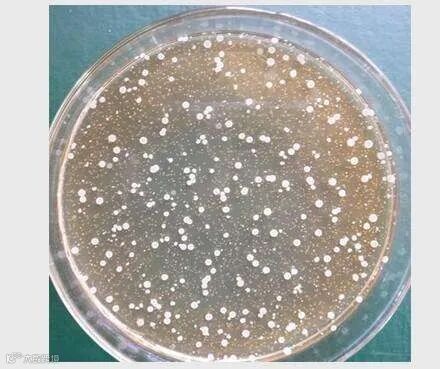
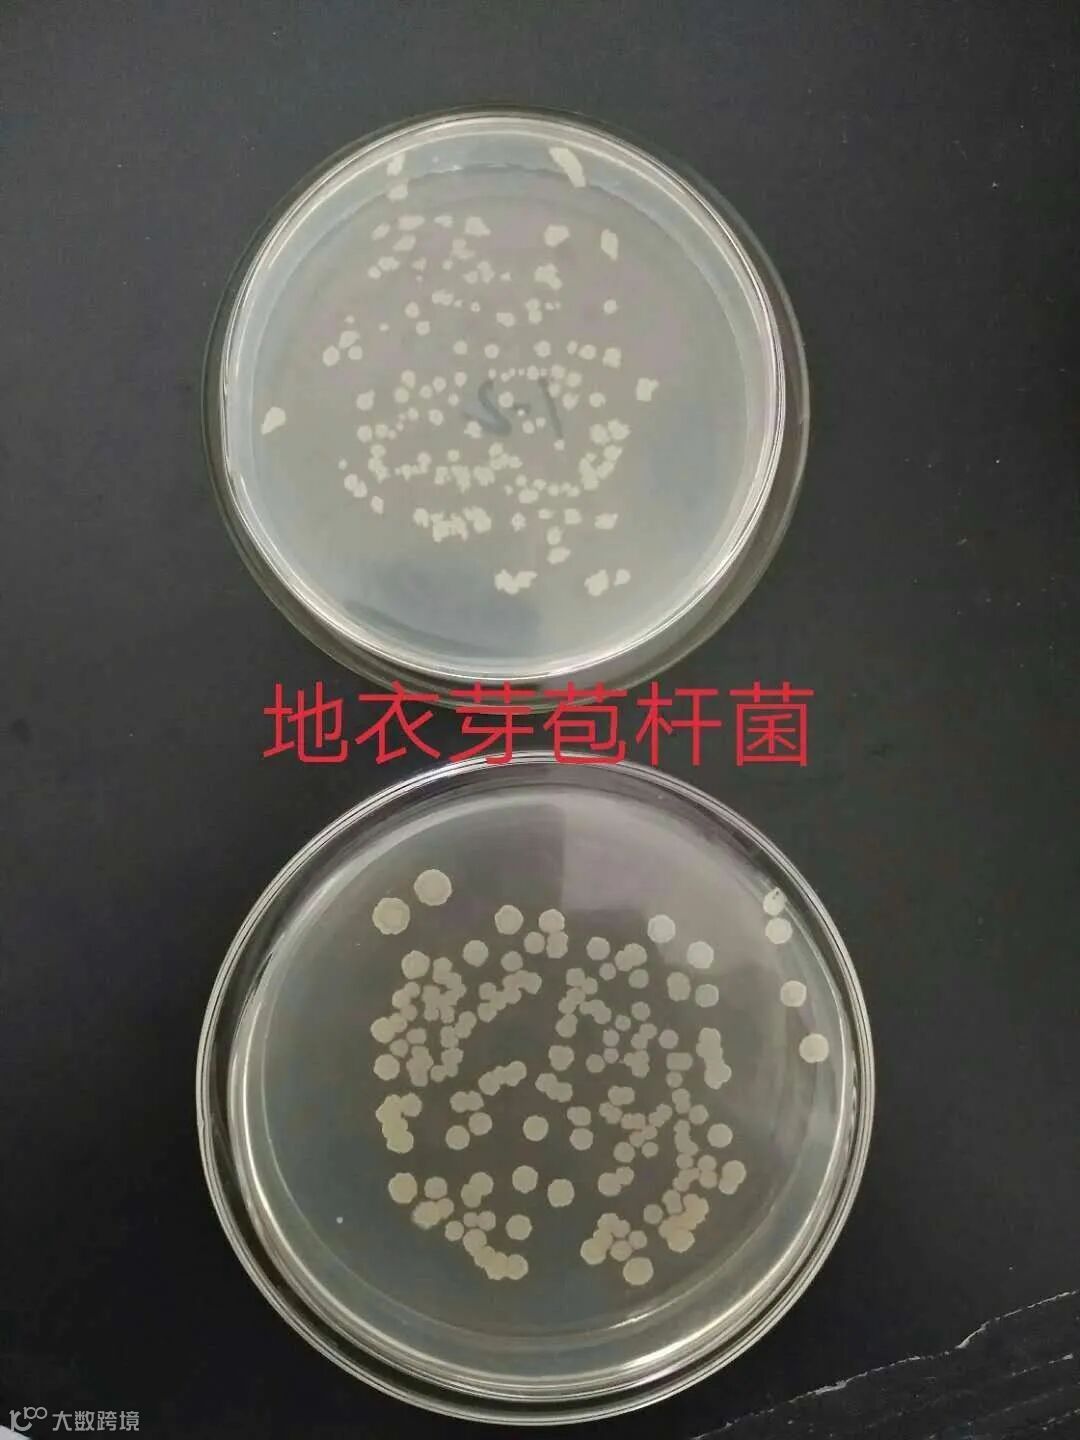

商品有机肥料是一种以畜禽粪便等有机物为主要原料,配以功能发酵菌剂,使其快速除臭、腐熟、脱水,再加入一定量功能性微生物菌种,经过发酵腐熟后制成的含有一定有机质和养分浓度的有机类肥料。


商品有机肥料经过除臭、灭菌、无害化和多种工艺技术的处理,充分腐熟发酵,不会烧苗。






开沟条施肥

开沟条施肥

打塘穴施肥

打塘穴施肥

打塘穴施肥

云南顺丰洱海环保科技股份有限公司生产的“洱海”牌系列有机肥料,从原料进厂,到成品出厂,到田间地头,全程历经10个关键质量控制点和“物理观测—化学分析—生物培养”综合测试指标的检验。大嫂告诉二嫂,顺丰有机肥料好!












(顺丰洱海环保股份销售部任健霖—供稿)